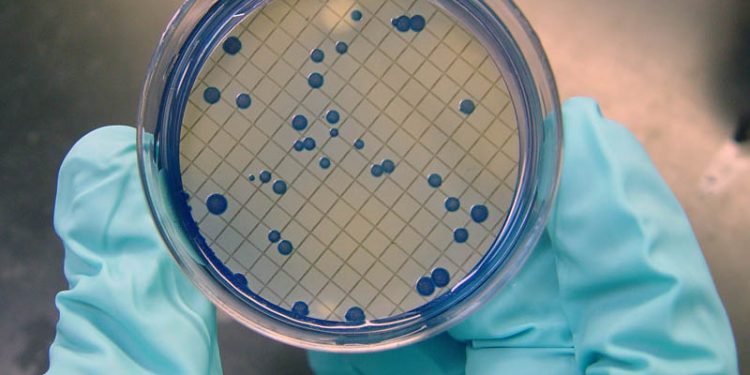
खानेपानीमा अत्यधिक ‘कोलीफर्म’ भेटियो

गल्याङ।स्याङ्जाका सबै स्थानीय तहमा खानेपानीमा ‘कोलीफर्म’ भेटिएको छ । जिल्लाका सबै स्थानीय तहमा खानेपानीका मुहानबाट पानीको नमूना संकलन गरेर परीक्षण गर्दा दिसामा देखिने जीवाणु ‘कोलीफर्म’ अध्यधिक मात्रामा भेटिएको हो ।
जिल्ला स्वास्थ्य कार्यालयका प्रमुख वसुन्धारा शर्माका अनुसार जिल्लाका ११ स्थानीय तहबाट खानेपानीका ९४ नमूना संकलन गरी परीक्षण गरिएको थियो । परीक्षण गरिएकामध्ये ४१ वटामा ‘कोलीफर्म’ भेटिएको हो । कार्यालयले पुतलीबजार र कालीगण्डकीमा १६–१६, भिरकोटमा १३, चापाकोट, वालिङ, आधीखोलामा आठ–आठ, बिरुवा र गल्याङ्मा छ–छ, अर्जुनचौपारीमा पाचँ, फेदीखोला र हरिनासमा चार–चार खानेपानीका नमूना संकलन गरी परीक्षण गरेको थियो ।
‘मुहान, ट्यांकी, धारा र घरबाट पानीको नमूना सङ¬्कलन गरेर परीक्षण गर्दा दिसामा हुने कोलीफर्मको कीटाणु अत्यधिक मात्रा पाइएको छ’, प्रमुख शर्माले भने, ‘सार्वजनिक, व्यक्तिगत र संस्थागत धाराबाट समेत पानीका नमूना परीक्षण गरिएका थिए ।’
सबैभन्दा बढी बिरुवा गाउँपालिकामा ६६ दशमलव छ प्रतिशत र सबैभन्दा कम पुतलीबजार नगरपालिकामा ३१ दशमलव २५ प्रतिशत कोलीफर्म भेटिएको छ । चापाकोट नगरपालिकामा ६२ दशमलव छ, फेदीखोला र हरिनास गाउँपालिकामा ५० दशमलवग ५०, भिरकोट नगरपालिकामा ४६ दशमलव एक, अर्जुनचौपारी गाउँपालिकामा ४० प्रतिशत कोलीफर्म भेटिएको प्रमुख शर्माले बताए । यस्तै गल्याङ नगरपालिकामा ३८ र वालिङ नगरपालिका, आँधीखोला र कालीगण्डकी गाउँपालिकामा ३७ दशमलव पाँच प्रतिशत कोलीफर्मका कीटाणु भेटिएका थिए ।
प्रमुख शर्माले गत वर्षको तुलनामा यस वर्ष पानीको शुद्धतामा केही प्रतिशत वृद्धि भएको बताएका छन् । उनले पानीको शुद्धता बढे पनि अत्यधिक कोलीर्फम भेटिनु सुखद् नतिजा नभएको उल्लेख गरे । गत आर्थिक वर्षमा जिल्लाका सबै पालिकाबाट खानेपानीको ५२ नमूना परीक्षण गरिएकामा ५२ प्रतिशत कोलीफर्म भेटिएको थियो । कोलीफर्मयुक्त पानी सेवनले झाडापखाला, टाइफाइडजस्ता सरुवा रोग लाग्नुका साथै मिर्गौलालाई पनि असर गर्छ ।